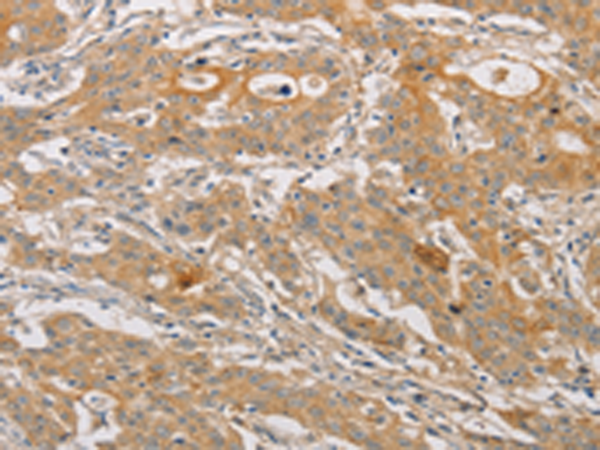

中文名稱:兔抗ARSK多克隆抗體
|
Background: |
Sulfatases (EC 3.1.5.6), such as ARSK, hydrolyze sulfate esters from sulfated steroids, carbohydrates, proteoglycans, and glycolipids. They are involved in hormone biosynthesis, modulation of cell signaling, and degradation of macromolecules. |
|
Applications: |
ELISA, IHC |
|
Name of antibody: |
ARSK |
|
Immunogen: |
Fusion protein of human ARSK |
|
Full name: |
arylsulfatase family, member K |
|
Synonyms: |
TSULF |
|
SwissProt: |
Q6UWY0 |
|
IHC positive control: |
Human gastric cancer and human liver cancer |
|
IHC Recommend dilution: |
50-200 |
購(gòu)物車
購(gòu)物車 幫助
幫助
 021-54845833/15800441009
021-54845833/15800441009
